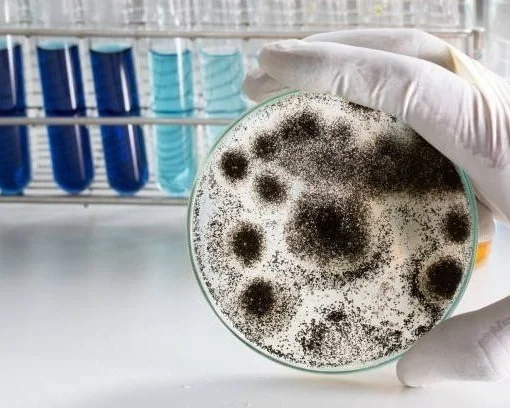

Services

Professional Home Inspection
Can be done for more than just buyers. Ask about scheduling a pre-listing inspection.
Whether you're purchasing your first home or your fifth, a professional home inspection is one of the most important steps in making an informed decision. My standard home inspection is a comprehensive, top-to-bottom evaluation of the home’s visible and accessible systems and components—including the structure, roof, plumbing, electrical, HVAC, and more.
As a licensed North Carolina home inspector, fully insured and trained to follow the InterNACHI Standards of Practice, I provide a thorough, unbiased assessment of the property’s condition. This inspection is designed to give you the insight you need to make an informed decision, negotiate with confidence, and plan for future maintenance or repairs.
You’ll receive a comprehensive digital report with clear descriptions, annotated photos, and objective recommendations—delivered promptly, typically by the next morning.
Visit the Standards of Practice for detailed guidelines on home inspections.

New Construction / Pre-Drywall
See what’s behind the walls—before they’re sealed for good
A pre-drywall inspection is a critical step in the new construction process. Once the walls go up, key components of your home—like plumbing, electrical wiring, HVAC systems, and structural framing—are no longer visible or easily accessible. This inspection offers a rare opportunity to identify potential issues early, before they’re covered up, helping you avoid costly repairs and gain peace of mind.
Unlike a quick walk-through, this is a thorough evaluation. I take the time to inspect all accessible areas and provide a detailed punch list your builder can use to make corrections before moving forward.
This inspection also serves as a valuable reference for future upgrades or DIY projects. Knowing where wires, pipes, and other systems are located makes future renovations safer and more efficient.
Ask about bundling this inspection with a final home inspection and an 11-month warranty inspection for complete coverage throughout your home’s first year..

“11 Month” Warranty Inspection
How’s the 1st year been?
Most new homes come with a one-year builder’s warranty that covers defects in materials, systems, and workmanship. An 11th-month warranty inspection is your opportunity to have the home professionally re-evaluated before that warranty expires.
This inspection includes a full re-check of the property’s major systems and components—including the structure, roof, plumbing, HVAC, and electrical—to identify any issues that may have developed during the first year of occupancy. I’ll also re-test systems and look for signs of settling, wear, or defects that may have been missed or have newly emerged.
You’ll receive a detailed digital report outlining warrantable defects and maintenance concerns, which you can submit directly to your builder’s warranty team—giving them time to make repairs while you’re still covered.

Manufactured & Mobile Homes
Mobile and manufactured homes require a specialized approach. While they share many systems with traditional homes, they’re built and assembled using different methods—and come with unique considerations related to structure, support, and mechanical systems.
This inspection includes a full evaluation of the home’s structure, roof, plumbing, electrical, HVAC, foundation or anchoring system, skirting, moisture intrusion risks, and other features specific to factory-built homes.
With extensive experience inspecting manufactured homes, I know what to look for and understand the construction methods and installation practices involved. I inspect with a deep understanding of how these homes function over time, referencing industry standards and best practices to identify potential concerns.
You’ll receive a clear, detailed digital report with annotated photos and practical recommendations—so you can move forward with clarity and confidence.
Mold Testing
If you suspect mold—or if the home inspection reveals conditions that could lead to mold growth—I offer professional mold testing to provide clear, lab-verified results. I collect air or surface samples from areas of concern and send them to a certified local lab for analysis.
You’ll receive a professionally prepared PDF report with visual breakdowns of mold types and quantities, individual spore and particulate counts, and microscope images of what was found. The report is well-organized and easy to understand, giving you the insight you need to decide on next steps with confidence.
Overnight shipping is available to help ensure next-day lab results when time is a factor.
Lab-backed mold testing provides peace of mind and objective data—whether you’re concerned about indoor air quality, preparing for a home purchase, or planning remediation.

Radon Testing
Radon is a naturally occurring radioactive gas that can seep into homes from the soil—and prolonged exposure is the second leading cause of lung cancer in the U.S. Because it’s colorless, odorless, and tasteless, the only way to know if radon is present is through testing.
I offer professional radon testing using calibrated, industry-standard equipment to measure levels over a 48-hour period. The test is placed in a key area of the home and left undisturbed to collect accurate readings under closed-house conditions.
Once the testing period is complete, you’ll receive a detailed digital report showing the average radon levels recorded, along with guidance on whether mitigation is recommended based on EPA action levels.
Radon testing is a simple, affordable step that can have a big impact on long-term health and peace of mind—especially when buying or selling a home.
Contact Me
Interested in scheduling an inspection or finding out more? Fill out some info and I will be in touch shortly. I can’t wait to hear from you!
Feel free to call or text me directly at (910)-406-8584

